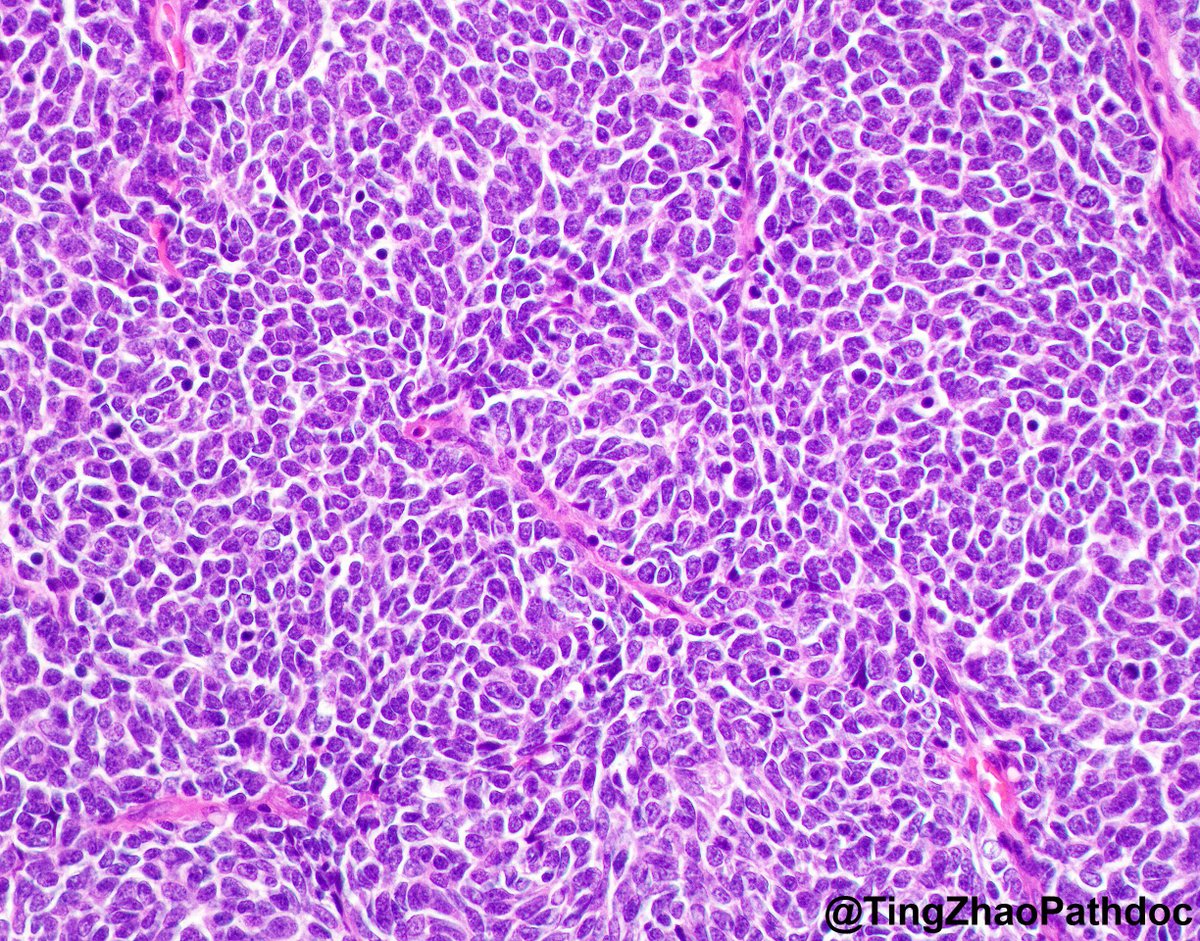
Ting Zhao, MD tweet media

Prasu M retweetledi
Prasu M
2K posts

Prasu M
@PM_path
Surgical pathologist; Former resident and surgpath fellow @Mayo Clinic; T/RT-not medical advice.
Katılım Ocak 2017
1.7K Takip Edilen2.5K Takipçiler
Prasu M retweetledi
Prasu M retweetledi

Hi #pathtwitter
Sorry I have been absent, but I have moved jobs!
I am now working in Perth, Australia for Pathwest and (soon for) @uwanews (as A/Prof).
Will get back to posting soon, in the meantime, here is an interesting colleague's case.
#GIpath #Endopath #Pathresidents




English
Prasu M retweetledi
Prasu M retweetledi

Breast-Challenges in diagnosis
Case diagnosed as invasive lobular carcinoma due to negativity for ecadherin
This lesion was also triple negative and CK negative
Patient had history of plasma cell neoplasm
Lambda stains were positive
Final diagnosis: metastasis of a plasma cell neoplasm
Dr. Sahin #USCAP25 #pathology #PathX

English
Prasu M retweetledi

Let’s enjoy this cutie which pops up often on RISE and board exams, but not so frequently under the microscope! Once you see it, you’ll never forget it!
A beautiful case of Sex Cord Tumor with Annular Tubules (SCTAT):
• Positive for Calretinin, Inhibin, and WT-1
• Approximately one-third of cases are associated with Peutz-Jeghers syndrome (STK11 mutation)
#PathX #GYNpath @UMiamiPathology



English
Prasu M retweetledi

Part 1 of 2: Voided urine, interpretation?
A) Negative for high grade
B) Atypical urothelial cells
#GUPath #PathTwitter #CytoPath #Pathology

English
Prasu M retweetledi

An often-forgotten figure in the history of chemotherapy is Yellapragada Subbarow, the Indian chemist who discovered aminopterin, a folic acid antagonist. Aminopterin became one of the first chemotherapy agents used by Sidney Farber in the 1940s to induce remission in children with acute lymphoblastic leukemia, marking a pivotal moment in cancer treatment. Despite his groundbreaking contributions to medical science, Subbarow was, if I’m not mistaken, never granted a permanent faculty appointment at Harvard Medical School
Miguel Reyes-Múgica@mreyesm
@Vik_deshpandeMD @DanaFarber @BIDMCpath Dr. Sidney Farber was a prominent #PediPath giant, head of Pediatric Pathology at Boston Children’s Hospital, who promoted and tried chemotherapy treatment for leukemias. That was the beginning of a major medical breakthrough!
English
Prasu M retweetledi
Prasu M retweetledi

Thank you all for taking part in the case I posted last Friday.
I chose one of the trickier fields to share with you, because of its educational value. The additional images provide more insight into the diagnosis.
Let's go over the answers 1 by 1🧵
#breastpath #PathTwitter




English
Prasu M retweetledi

Hi @pathology friends!
Consult: Thoracic tumor.
Exactly all of the information available to us.
TTF-1 and p40 negative. What’s next? 🤔
#NatPathPuzzler #PulmPath @PulmPathSoc


English
Prasu M retweetledi

Prasu M retweetledi

40F, last menstrual period 15 days ago, history of abnormal pap.
What is your interpretation?
A) Benign endometrial cells
B) AGC, endometrial
C) AGC, endocervical
D) HSIL
#CytoPath #GynPath #PathTwitter #Pathology
🖼️bethesda.soc.wisc.edu/index.htm

English
Prasu M retweetledi

👉71 YO male with urinary bladder mass.
[A] is section from the mass.
[B] was an incidental finding among the tumor.
[C] demonstrates IHC done in that area. PAX8 was negative.
What is the diagnosis as seen in A?
What is B?
Courtesy @annsmiley78
#PathTwitter #GUpath #Surgpath #Pathology



English
Prasu M retweetledi

For pathology residents stressing out about fellowship applications (or which subspecialty to pursue), this talk (and associated book) might be helpful... #UMichPath #pathology
ted.com/talks/david_ep…
English
Prasu M retweetledi
Prasu M retweetledi
Prasu M retweetledi
Prasu M retweetledi
Prasu M retweetledi

Liver metastasis in adult.
Diagnosis? AE1/AE3 and Ki67 in next tweet.
Can you tell the origin of the tumour?
#pathology




English